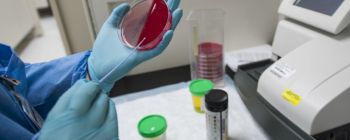
Чи буде у вас хвороба Альцгеймера за 30 років? Відповідь в вашій крові

Вчені відвертають хворобу Альцгеймера у мишей

Майбутній прорив?
Дослідники змогли повернути назад освіту амілоїдних бляшок, які поступово вбивають нейрони у пацієнтів з хворобою Альцгеймера, в мозку мишей - істотно змінюючи стан.
Поряд зі зменшенням бляшок, які погіршують зв'язок між клітинами мозку, миші також відчували когнітивне поліпшення. Команда з Клівлендського клінічного дослідницького інституту Лернера в США докладно розповіла про результати в Журналі експериментальної медицини. Автори досягли багатообіцяючого набору результатів, поступово виснажуючи фермент, який відіграє певну роль в утворенні бляшок, відомих як BACE1.
Доказ концепції
Один з найбільш конкретних способів ідентифікації Альцгеймера у пацієнта полягає в аномальному накопиченні бета-амілоїдного пептиду, білка, який може вбудовуватися в великі амілоїдні бляшки в мозку, які є достовірною ознакою смертельної, і до теперішнього часу невиліковна хвороба. BACE1 допомагає продукувати бета-амілоїдних пептид, і тому інгібування ферменту ліками може в кінцевому рахунку відкрити двері для ефективних методів лікування Альцгеймера, припинивши нарощування.

Миша з хворобою Альцгеймера хвороба (ліворуч) показує червоні амілоїдні бляшки і зелені активовані клітини мікроглії. Справа знаходиться мозок миші, який поступово втратив BACE1. Зображення: Hu et al., 2018
Дослідники протестували гіпотезу, розробивши групу мишей, які втрачають фермент BACE1 в міру дорослішання. І хоча у мишей, у яких був відсутній фермент, було виявлено, що вони страждають важкими неврологічними дефектами, ті, хто припинив його виробництво з плином часу, залишалися здоровими.
Щоб дізнатися, як цей новий генетичний макіяж діє проти хвороби Альцгеймера, дослідники потім розводять своїх здорових мишей з іншими людьми, сконструйованими для розвитку хвороби. Вони виявили, що в той час як амілоїдні бляшки почали накопичуватися в мозку потомства, вони також зникли, так як миші поступово втрачали фермент BACE1.
Довгий шлях вперед
Однак автори пояснюють, що такі багатообіцяючі результати не приходять без застережень. По-перше, експеримент був проведений тільки в моделі миші, тому немає ніякої гарантії, що зіставні результати будуть досягнуті у людей. Крім того, BACE1 бере участь у багатьох інших важливих процесах в організмі, а препарати, які поступово руйнують його, можуть мати серйозні побічні ефекти.
Лікування хвороби Альцгеймера - складний і часто несамовитий процес, і це дослідження не є ні дивом, ні пропущеної метою. Це може бути тільки першим кроком на шляху до реалізації такого ефективного лікування, але, з огляду на ранні результати, це доцільний шлях.
Джерела: Medicalxpress, JEM